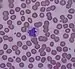

白血球
白血球(英語:),又稱為白細胞,是血液中重要的血细胞之一。除白血球外,人体血液中还含有紅血球、血小板和血浆。白血球雖命名「白」,但其實際上是黑色的 。
| 白血球 | |
|---|---|
![]() | |
| 基本 | |
| 系統 | 免疫系统 |
| 标识字符 | |
| 拉丁文 | leucocytus |
| 縮寫 | WBC |
| MeSH | D007962 |
| TH | H2.00.04.1.02001 |
| FMA | FMA:62852 |
| 《显微解剖学术语》 | |
白血球是免疫系统的一部分,帮助身体抵抗传染病以及外来的东西。白血球可以由骨髓的造血幹細胞產生[1]。白血球有核,能作变形运动,正常情况下白血球在健康成人体内的濃度为每升血液4×109到11×109個。白血球作为免疫细胞,在机体发生癌症或其他疾病时,血液内的白血球总数或细胞分类百分比可有变化。
白细胞种类

扫描型电子显微镜照片。嗜中性白细胞吞噬炭疽杆菌。颜色为图像处理时着色,真正的是没有颜色的
粒细胞
粒细胞的細胞質中含有若干微小囊性颗粒,颗粒中则贮有多种酶。按照颗粒的染色性质可分为:
- 中性粒细胞:佔白血球總數70~80%,當有發炎反應時是第一個主動來參與的細胞。
- 嗜酸性粒细胞:可協助身體對抗引起過敏的過敏原,亦具有吞噬能力。
- 嗜碱性粒细胞:嗜鹼性白血球主要引發過敏反應,釋放組織胺並造成平滑肌收縮、血管舒張等等。
无粒白细胞
定居的白细胞
参考文献
- Maton, D., Hopkins, J., McLaughlin, Ch. W., Johnson, S., Warner, M. Q., LaHart, D., & Wright, J. D., Deep V. Kulkarni. . Englewood Cliffs, New Jersey, US: Prentice Hall. 1997. ISBN 0-13-981176-1.
- . [2014-08-04]. (原始内容存档于2021-05-24).
- Unless else specified in boxes, then ref is: Alberts, Bruce. . Molecular Biology of the Cell. NCBI Bookshelf. 2005 [2007-04-14].
- Unless else specified in boxes, then ref is: Semester 4 medical lectures at Uppsala University 2008 by Leif Jansson
- Semester 4 medical lectures at Uppsala University 2008 by Leif Jansson
This article is issued from Wikipedia. The text is licensed under Creative Commons - Attribution - Sharealike. Additional terms may apply for the media files.